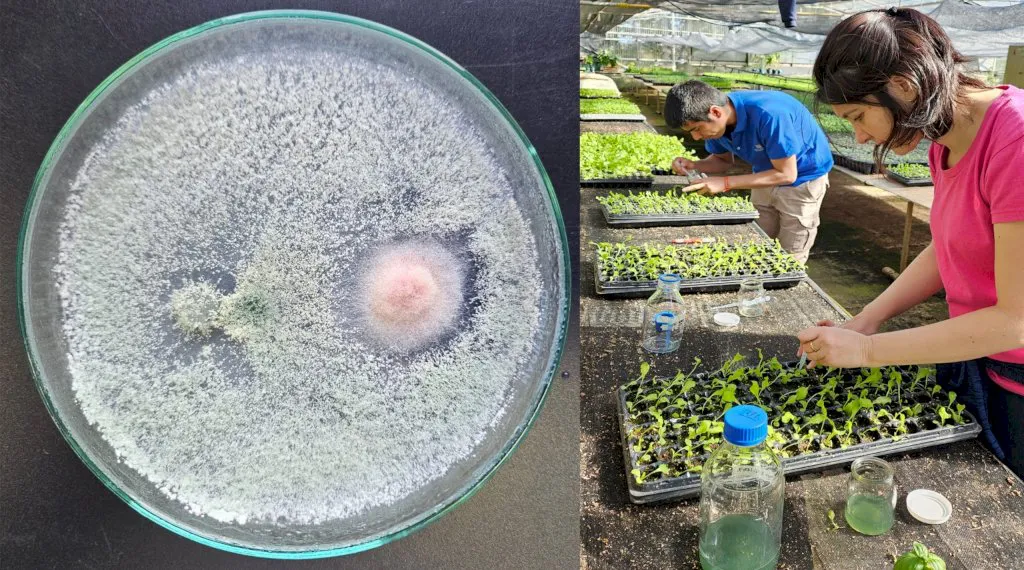
whatsapp image 2025-08-07 at 12.15.56_1754579808

Ushuaia será sede del II Festival Internacional de Cine Ambiental en noviembre
Durante el mes de noviembre se llevará adelante en la ciudad de Ushuaia el II Festival Internacional de Cine Ambiental organizado por la Asociación Manekenk. Este festival es la continuación de la Muestra Internacional de Cine Ambiental Independiente que se llevó adelante de forma ininterrumpida desde el año 2012 hasta 2022.